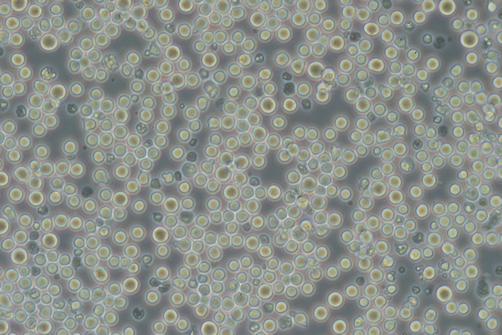

ID |
TKG 0146 |
Cell name |
Gardner lymphoma 6C3HED/OG |
Data accepted |
|
Animal |
Mouse (C3H/He) |
Scientific name |
Mus musculus |
Sex |
|
Case history |
Sensitive to asparaginase, mode=64. |
Tissue |
Lymphoma. |
Genetics |
mode=64 |
Life span |
Infinite. |
Morphology |
|
Medium |
RPMI-1640 + 10% FBS. |
Passage method |
Dilution (1/3 every 3-4days) |
Characteristics |
This tissue culture cell line was established from a
cell line maintained by in vivo transplantation. Culture cell line was found to be contaminated with mycoplasma. Progeny
were cured by Treatments with BM Cyclin and MC210. Conditions for transplantation,
ip:100:12-14 (transplantation site : transplantation rate : survival days).
|
Temperature |
37℃ |
CO2 concentration |
5% |
Subculture frequency |
|
Classification |
|
Mycoplasma |
PCR: -, Hoechst DNA staining: - |
Isozyme analysis |
LD |
Established by |
|
References |
Surgery,
87, 190-201, 1980.PMID: 6892581 BBA,
600, 321-331, 1980.PMID: 7407116 J.
Immunol., 123, 2725-2728, 1979.PMID: 115920 J.
Immunol., 122, 379-382, 1979.PMID: 581674 J.
Immunol., 122, 70-74, 1979.PMID: 762424 J.
Exp. Med., 148, 93-102, 1978.PMID: 353219 JNCI,
61, 415-421, 1978.PMID: 277729 J.
Immunol., 118, 175-179, 1977.PMID: 299754 Ann. NY. Acad. Sci., 276, 61-74, 1976. PMID: 1071980 |
References by users |
|
Deposited by |
|
Restriction |
|
Photo |
|